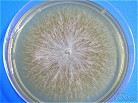

Agentes de Micoses Superficiais
(clique nas imagens para ampliar)
Agentes de Dermatofitose: Dermatófitos
Exame direto no pêlo
Parasitismo endotrix Parasitismo
ectotrix

 
Dermatofitose
Exame direto em escamas epidérmicas e ungueais
 

 


Dermatófitos
Microsporum canis
 

Trichophyton mentagrophytes
 

 
Epidermophyton floccosum
Microsporum gypseum
 
Trichophyton rubrum
 
Trichophyton tonsurans
 

Agente de piedra branca: Trichosporon sp
Exame direto do pêlo
 
 

Aspectos micromorfológicos

Agente de Tinea nigra : Hortaea werneckii
Exame direto
 

 
Agente de Piedra nigra : Piedraia hortae
Exame direto do pêlo
 


Agentes de Pitiríase versicolor: Malassezia
spp
Exame direto
 

 
Agente de Eritrasma: Corynebacterium minutissimum
Exame direto
 

Candidíase Ungueal : agentes Candida
spp
Exame direto
 
|
